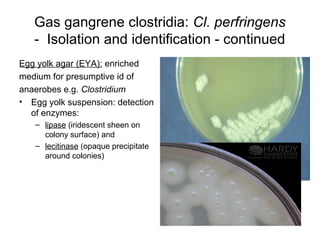
Gas gangrene clostridia: Cl. perfringens
- Isolation and identification - continued
Egg yolk agar (EYA): enriched
medium for presumptive id of
anaerobes e.g. Clostridium
• Egg yolk suspension: detection
of enzymes:
– lipase (iridescent sheen on
colony surface) and
– lecitinase (opaque precipitate
around colonies)

This document discusses laboratory diagnosis of infections caused by obligate anaerobic bacteria. It defines various types of bacteria based on their ability to grow with or without oxygen. Obligate anaerobes cannot grow in the presence of oxygen because they lack enzymes like superoxide dismutase and catalase to break down harmful oxygen byproducts. Specimen collection and transport methods aim to maintain an oxygen-free environment. Identification techniques for certain pathogenic anaerobes that cause infections like gas gangrene, tetanus, and botulism are also outlined.